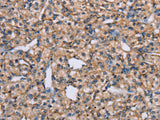
ADAM29 Polyclonal Antibody

ADAM29 Polyclonal Antibody
SKU: E-AB-12946-200
ADAM29 Polyclonal Antibody
| SKU # | E-AB-12946 |
| Reactivity | Human |
| Host | Rabbit |
| Applications | IHC |
Product Details
| Isotype | IgG |
| Host | Rabbit |
| Reactivity | Human |
| Applications | IHC |
| Clonality | Polyclonal |
| Immunogen | Synthetic peptide of human ADAM29 |
| Abbre | ADAM29 |
| Synonyms | A disintegrin and metalloproteinase domain 29, ADA29, ADAM 29, ADAM metallopeptidase domain 29, ADAM29, CT73, Cancer/testis antigen 73, Disintegrin and metalloproteinase domain-containing protein 29, Metallaproteinase disintegrin (ADAM29), svph1 |
| Swissprot | |
| Cellular Localization | Membrane. |
| Concentration | 0.4 mg/mL |
| Buffer | Phosphate buffered solution, pH 7.4, containing 0.05% stabilizer and 50% glycerol. |
| Purification Method | Affinity purification |
| Research Areas | Cell Biology, Signal Transduction |
| Conjugation | Unconjugated |
| Storage | Store at -20°C Valid for 12 months. Avoid freeze / thaw cycles. |
| Shipping | The product is shipped with ice pack,upon receipt,store it immediately at the temperature recommended. |
Related Reagents
| Applications | Recommended Dilution |
| IHC | 1:50-1:200 |
Background
This gene encodes a member of the ADAM (a disintegrin and metalloprotease domain) family.Members of this family are membrane-anchored proteins structurally related to snake venom disintegrins, and have been implicated in a variety of biological processes involving cell-cell and cell-matrix interactions, including fertilization, muscle development, and neurogenesis.The protein encoded by this gene is highly expressed in testis and may be involved in human spermatogenesis.Alternative splicing results in multiple transcript variants that encode the same protein.